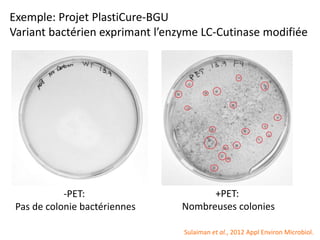
Exemple: Projet PlastiCure-BGU
Variant bactérien exprimant l’enzyme LC-Cutinase modifiée
-PET:
Pas de colonie bactériennes
+PET:
Nombreuses colonies
Sulaiman et al., 2012 Appl Environ Microbiol.

Le document explore la résilience et les défis écologiques dans l'anthropocène, mettant en lumière les effets de l'activité humaine sur la nature et les questions d'échelle concernant les ressources. Il évoque des exemples historiques et contemporains de la dépendance aux machines et aux technologies tout en discutant de l'importance de l'économie circulaire et de la bioéconomie. Enfin, il aborde la notion de sous-optimalité biologique comme un modèle potentiel pour une société résiliente.